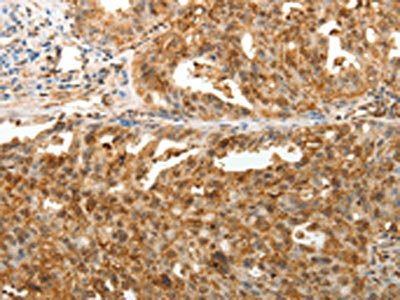

TENM3 Antibody
-
中文名稱:TENM3兔多克隆抗體
-
貨號(hào):CSB-PA012753
-
規(guī)格:¥1100
-
圖片:
-
The image on the left is immunohistochemistry of paraffin-embedded Human esophagus cancer tissue using CSB-PA012753(TENM3 Antibody) at dilution 1/50, on the right is treated with synthetic peptide. (Original magnification: ×200)
-
The image on the left is immunohistochemistry of paraffin-embedded Human ovarian cancer tissue using CSB-PA012753(TENM3 Antibody) at dilution 1/50, on the right is treated with synthetic peptide. (Original magnification: ×200)
-
-
其他:
產(chǎn)品詳情
-
Uniprot No.:
-
基因名:TENM3
-
別名:FLJ10474 antibody; FLJ10886 antibody; KIAA1455 antibody; odd Oz Ten m homolog 3 antibody; odz odd Oz ten m homolog 3 (Drosophila) antibody; odz odd Oz ten m homolog 3 antibody; ODZ3 like protein antibody; Protein Odd Oz ten m homolog 3 antibody; Protein Odd Oz/ten-m homolog 3 antibody; Ten 3 antibody; Ten M3 antibody; Ten-3 antibody; Ten-m3 antibody; TEN3_HUMAN antibody; Tenascin M3 antibody; Tenascin-M3 antibody; Teneurin 3 antibody; Teneurin transmembrane protein 3 antibody; Teneurin-3 antibody; Teneurin3 antibody; tenm3 antibody; TNM3 antibody
-
宿主:Rabbit
-
反應(yīng)種屬:Human,Mouse
-
免疫原:Synthetic peptide of Human TENM3
-
免疫原種屬:Homo sapiens (Human)
-
標(biāo)記方式:Non-conjugated
-
抗體亞型:IgG
-
純化方式:Antigen affinity purification
-
濃度:It differs from different batches. Please contact us to confirm it.
-
保存緩沖液:-20°C, pH7.4 PBS, 0.05% NaN3, 40% Glycerol
-
產(chǎn)品提供形式:Liquid
-
應(yīng)用范圍:ELISA,IHC
-
推薦稀釋比:
Application Recommended Dilution ELISA 1:3000-1:10000 IHC 1:50-1:200 -
Protocols:
-
儲(chǔ)存條件:Upon receipt, store at -20°C or -80°C. Avoid repeated freeze.
-
貨期:Basically, we can dispatch the products out in 1-3 working days after receiving your orders. Delivery time maybe differs from different purchasing way or location, please kindly consult your local distributors for specific delivery time.
-
用途:For Research Use Only. Not for use in diagnostic or therapeutic procedures.
相關(guān)產(chǎn)品
靶點(diǎn)詳情
-
功能:Involved in neural development by regulating the establishment of proper connectivity within the nervous system. Acts in both pre- and postsynaptic neurons in the hippocampus to control the assembly of a precise topographic projection: required in both CA1 and subicular neurons for the precise targeting of proximal CA1 axons to distal subiculum, probably by promoting homophilic cell adhesion. Required for proper dendrite morphogenesis and axon targeting in the vertebrate visual system, thereby playing a key role in the development of the visual pathway. Regulates the formation in ipsilateral retinal mapping to both the dorsal lateral geniculate nucleus (dLGN) and the superior colliculus (SC). May also be involved in the differentiation of the fibroblast-like cells in the superficial layer of mandibular condylar cartilage into chondrocytes.
-
基因功能參考文獻(xiàn):
- This report supports the association of TENM3 mutations with colobomatous microphthalmia and expands the phenotypic spectrum associated with mutations in this gene PMID: 27103084
- Null mutation in ODZ3 causes autosomal recessive microphthalmia in humans. PMID: 22766609
-
相關(guān)疾病:Microphthalmia, isolated, with coloboma, 9 (MCOPCB9)
-
亞細(xì)胞定位:Cell membrane; Single-pass membrane protein. Cell projection, axon.
-
蛋白家族:Tenascin family, Teneurin subfamily
-
組織特異性:Expressed in adult and fetal brain, slightly lower levels in testis and ovary, and intermediate levels in all other peripheral tissues examined. Not expressed in spleen or liver. Expression was high in brain, with highest levels in amygdala and caudate nu
-
數(shù)據(jù)庫(kù)鏈接:
Most popular with customers
-
-
YWHAB Recombinant Monoclonal Antibody
Applications: ELISA, WB, IHC, IF, FC
Species Reactivity: Human, Mouse, Rat
-
Phospho-YAP1 (S127) Recombinant Monoclonal Antibody
Applications: ELISA, WB, IHC
Species Reactivity: Human
-
-
-
-
-